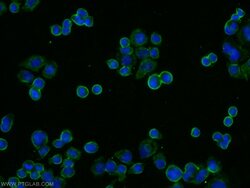

Antibody data
- Antibody Data
- Antigen structure
- References [0]
- Comments [0]
- Validations
- Western blot [2]
- Immunocytochemistry [2]
- Flow cytometry [1]
Submit
Validation data
Reference
Comment
Report error
- Product number
- 13462-1-AP - Provider product page

- Provider
- Invitrogen Antibodies
- Product name
- IL22RA1 Polyclonal Antibody
- Antibody type
- Polyclonal
- Antigen
- Other
- Reactivity
- Human, Mouse, Rat
- Host
- Rabbit
- Isotype
- IgG
- Vial size
- 150 µL
- Concentration
- 0.53 mg/mL
- Storage
- -20°C
No comments: Submit comment
Supportive validation
- Submitted by
- Invitrogen Antibodies (provider)
- Main image

- Experimental details
- Various lysates were subjected to SDS PAGE followed by western blot with 13462-1-AP (IL22RA1 antibody) at dilution of 1:2000 incubated at room temperature for 1.5 hours.
- Submitted by
- Invitrogen Antibodies (provider)
- Main image

- Experimental details
- HEK-293 cells were subjected to SDS PAGE followed by western blot with 13462-1-AP (IL22RA1 antibody) at dilution of 1:200 incubated at room temperature for 1.5 hours.
Supportive validation
- Submitted by
- Invitrogen Antibodies (provider)
- Main image

- Experimental details
- Staining of IL22RA1 (Cat#13462-1-AP) (2ryAbisA647) on FFPE human gut. The nuclei were counter stained with DAPI (in blue). The IL22RA1 signal is localized in the epithelial compartment which is expected. (Data from Manuel Florez, Laboratory Dre. Naglaa Shoukry, CRCHUM).
- Submitted by
- Invitrogen Antibodies (provider)
- Main image
- Experimental details
- Immunofluorescent analysis of COLO 320 cells using 13462-1-AP (IL22RA1 antibody) at dilution of 1:25 and Alexa Fluor 488-conjugated AffiniPure Goat Anti-Rabbit IGG (H+L).
Supportive validation
- Submitted by
- Invitrogen Antibodies (provider)
- Main image

- Experimental details
- 1X10^6 HepG2 cells were stained with .2ug IL22RA1 antibody (13462-1-AP, red) and control antibody (blue). Fixed with 4% PFA blocked with 3% BSA (30 min). Alexa Fluor 488-conjugated AffiniPure Goat Anti-Rabbit IGG (H+L) with dilution 1:1500.